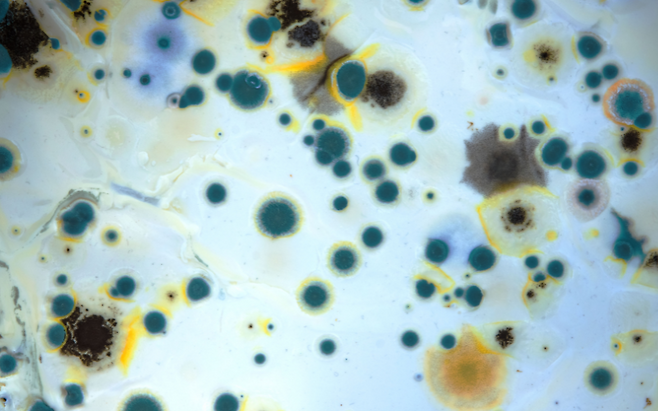

바나나는 익을수록 껍질이 점점 검게 변합니다
대부분의 사람들은 바나나 껍질이 까매져도 ‘속만 괜찮으면 먹어도 된다’고 생각합니다. 하지만 검게 변한 바나나, 특히 껍질에 점처럼 생긴 반점이 진해졌다면 주의가 필요합니다. 잘못 보관된 바나나는 건강에 해로울 수 있습니다.
껍질이 검어졌다고 모두 안전한 건 아닙니다

바나나 껍질이 검게 변하는 것은 자연스러운 후숙 과정이지만, 지나치게 진해지거나 물컹한 상태라면 곰팡이균이나 유해 세균이 증식한 것일 수 있습니다.
특히 껍질이 터져 안쪽까지 갈라져 있다면 이미 세균이 침투했을 가능성이 큽니다. 이 상태의 바나나는 표면뿐 아니라 과육까지 오염돼 식중독, 설사, 복통 등을 유발할 수 있습니다.
고온·다습한 환경에서 곰팡이 독소가 생기기도 합니다
여름철 바나나는 실온에서 금세 과숙 상태에 이릅니다. 특히 30도 이상의 고온에서 보관된 바나나는 겉은 괜찮아 보여도 내부에서 아플라톡신 같은 곰팡이 독소가 생성될 수 있습니다.
이 독소는 간에 치명적이며, 지속 섭취 시 간암의 원인이 될 수 있어 각별한 주의가 필요합니다.
검게 익은 바나나, 이렇게 구별하세요

껍질에 반점이 생겼더라도 단단하고 탄력이 있다면 섭취해도 괜찮습니다. 하지만 껍질이 흐물흐물하거나 벌레가 꼬이는 냄새가 난다면 바로 폐기해야 합니다.
먹기 직전 냄새, 촉감, 색깔을 꼭 확인하는 습관이 중요합니다. 특히 껍질이 터졌거나 곰팡이가 핀 경우엔 절대 먹지 말아야 합니다.

바나나는 후숙 과일이지만 지나치게 익은 상태는 건강을 위협할 수 있습니다. 껍질이 검어졌다고 무조건 먹는 건 위험한 판단입니다.
특히 여름철엔 바나나를 서늘하고 통풍 잘 되는 곳에 보관하고, 이상 징후가 보이면 과감하게 버리는 것이 현명합니다. 작은 부주의가 큰 질병으로 이어질 수 있습니다.
Copyright © 뇌생각